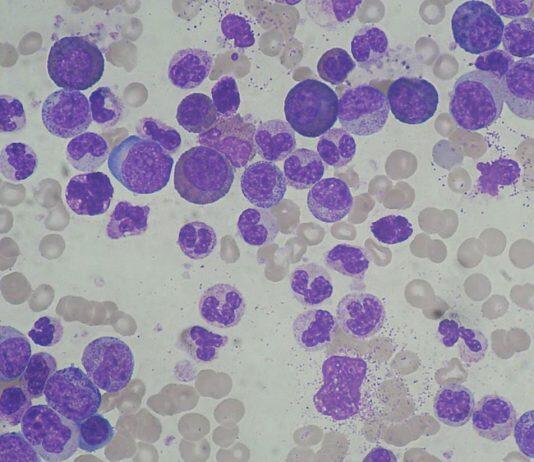
英国赫尔约克医学院发现白血病细胞的遗传倾向

中国科学技术大学与泰国科技发展署(NSTDA)举行国际合作专题视频会议
2021年1月15日上午,中国科学技术大学与泰国科技发展署(NSTDA)举行国际合作专题视频会议,会议由国际合作与交流部部长瞿昆主持。
澳门大学举办首届镜海人文圆桌研讨会并发表多项研究成果
为促进师生间的学术合作与交流,澳门大学人文学院举办第一届镜海人文圆桌研讨会,由学院各学系发表研究成果报告,涵盖文学、历史、哲学、语言学、翻译、教育等人文领域,吸引众多师生现场参与,反应十分热烈。
中国教育部:70个国家将中文纳入国民教育体系
在教育部12月22日召开的新闻发布会上,教育部国际合作与交流司司长、港澳台办公室主任刘锦介绍,聚焦“一带一路”,2019年在我国学习的“一带一路”沿线国家留学生占比达54.1%。
第二届中德纺织与时尚论坛成功举办
2020年12月15日,东华大学管理学院与德国路特林根技术大学联合在线举行了第二届中德纺织与时尚论坛(2nd Chinese-German Textiles and Fashion Seminar)。